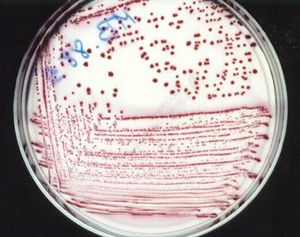
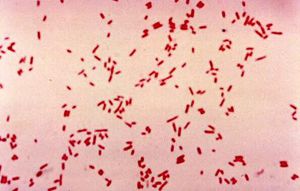

إشريكية قولونية
| د. وائل شرف |
| المساهمة الرئيسية في هذا المقال |
الإشريكية القولونية Escherichia coli (E. coli)
هي جزء من الفلورا الطبيعية في القولون عند البشر وعند بعض الحيوانات، لكن يمكن أن تصبح ممرضة داخل وخارج السبيل الهضمي. وتتعلق الاختلافات في درجة فوعة سلالات الإشريكية القولونية باستملاكها للبلاسميدات، وطليعيات العاثية المدمجة معها والإمراضية.
وهي جراثيم سلبية الغرام لا هوائية مخيرة عصوية الشكل، تكون غير ممرضة عادةً.
لدى الإشريكية القولونية خمل أو أهداب، هذه الأهداب ذات أهمية في الالتصاق بالأسطح المخاطية للمضيف، وتختلف السلالات من ناحية الحركة، فبعضها متحرك وبعضها لا.
تستطيع معظم السلالات تخمير اللاكتوز، بخلاف معظم الجراثيم الممرضة المعوية، مثل السالمونيلة والشيغيلة التي لا تستطيع ذلك. وتنتج الإشريكية القولونية كلاً من الحمض والغاز أثناء تخمير السكريات.
أول من وصفها كان ثيودور إشريك عام 1885.
لمحة عامة
تُعَد الإشريكية القولونية أحد الأسباب الأكثر شيوعًا للعديد من العداوى الجرثومية الشائعة، بما فيها ذلك التهاب المرارة cholecystitis وتجرثم الدم bacteremia والتهاب الأقنية الصفراوية cholangitis وعدوى السبيل البولي (UTI) وإسهال المسافرين وعداوى سريرية أخرى كالتهاب السحايا الوليدي neonatal meningitis وذات الرئة pneumonia.
سُمِّي جنس الإشريكية تكريمًا لـ Theodor Escherich، والذي عزل النوع النمط للجنس.
إن كائنات الإشريكية عصيات سلبية الغرام وتوجد منفردة أو كأزواج. وهي لاهوائية مخيرة مع نمط استقلاب تخمري وتنفسي على حد سواء، وهي إما أن تكون غير متحركة أو متحركة بوساطة السياط المحيطية.
تُعَد الإشريكية القولونية مستوطِنًا مخيرًا رئيسًا في الأمعاء الغليظة.
البنية والفيزيولوجية
تشترك الإشريكية القولونية في كثيرٍ من الخواص مع باقي الإمعائيات. فجميعها لا هوائيات مخيرة، وجميعها تخمر الغلوكوز، وجميعها تستطيع توليد الطاقة بالتنفس الهوائي أو اللاهوائي (باستخدام النترات أو النتريت أو الفومارات كمستقبلات طرفية للكربون).
وتفتقر جميعها للسيتوكروم C أوكسيداز (أي أنها سلبية على الأوكسيداز).
يقوم تنميط السلالات على أساس الاختلافات في 3 مستضدات بنيوية، وهي: O و H و K:
- توجد المستضدات O (المستضدات الجسمية، أو مستضدات الجدار الخلوي) على القسم السكري من عديد السكريد الشحمي. هذه المستضدات ثابتة للحرارة ويمكن أن تكون مشتركة بين أجناس الإمعائيات. ومن الشائع استخدام المستضدات O في التنميط المصلي لكثير من العصيات المعوية سلبية الغرام.
- المستضدات H لها علاقة بالسياط، ولذلك فقط الإمعائيات المتحركة (ذات السياط) مثل الإشريكية القولونية لديها هذه المستضدات.
- تتوضع المستضدات K ضمن محافظ عديدة السكريد.
ومن بين أنواع الإشريكية القولونية هنالك كثير من المستضدات O و H و K المتمايزة، وأنماط مصلية معينة ترتبط بأمراض معينة. فمثلاً الزمرة المصلية للإشريكية القولونية التي تمتلك المستضد O157:H7 تسبب شكلاً شديداً من التهاب القولون النزفي.
الفيزيولوجيا المرضية
التهاب السحايا عند حديثي الولادة
تعد الإشريكية القولونية سبباً أساسياً لهذا المرض الذي يحدث في الشهر الأول من حياة الرضيع. يرتبط المستضد المحفظي K1 المطابق كيميائياً للمحفظة عديدة السكاريد للمجموعة B من النيسيرية السحائية على وجه الخصوص مع عداوى مماثلة.
التهاب السحايا الجرثومي الحاد Acute bacterial meningitis
إن الغالبية العظمى من حالات التهاب السحايا الوليدي تسببها الإشريكية القولونية والعداوى الناجمة عن عقديات المجموعة B (28.5% و34.1% عمومًا، على التوالي). إن النساء الحوامل معرضات بصورة أكبر لخطر تشكل مستعمرات ذرية المستضد المحفظي K1 للإشريكية القولونية.
تُلاحَظ هذه الذرية أيضًا عادة في تعفن الدم الوليدي neonatal sepsis الذي يملك معدل وفيات يبلغ 8%، حيث يعاني معظم الناجين من شذوذات عصبية أو نمائية لاحقة. يُنذِر انخفاض وزن المولود وإيجابية زرع السائل الدماغي الشوكي (CSF) بنتيجة سيئة.
يُعَد التهاب السحايا بالإشريكية القولونية لدى البالغين نادرًا ولكنه يمكن أن يحدث بعد إجراءات أو رضح الجراحة العصبية أو مضاعفات العدوى المفرِطة بالأسطوانيات البرازية Strongyloides stercoralis hyperinfection التي تكتنف الجهاز العصبي المركزي.
ذات الرئة Pneumonia
تُعَد عداوى السبيل التنفسي بالإشريكية القولونية غير شائعة وتترافق بصورة دائمة تقريبًا مع عدوى السبيل البولي بالإشريكية القولونية. ما من عوامل فوعة متورطة في ذلك. قد تنتج ذات الرئة بالإشريكية القولونية أيضًا من الشفط الدقيق لإفرازات المسلك الهوائي العلوي التي استُعمِرت سابقًا بهذا الكائن الحي لدى المرضى المصابين بشدة، ولذلك فإنها سبب لذات الرئة المستشفوية nosocomial pneumonia. ومع ذلك، قد تكون ذات الرئة بالإشريكية القولونية أيضًا مكتسبة من المجتمع community-acquired لدى المرضى الذين يعانون من مرض مستبطن كالداء السكري والكحولية والداء الرئوي المُسِدّ المزمن وعدوى السبيل البولي بالإشريكية القولونية.
تظهر ذات الرئة بالإشريكية القولونية عادة على شكل التهاب قصبي رئوي في الفصوص السفلية وقد تتسبب الدُبَيلة empyema بحدوث مضاعفات.
إن تجرثم الدم بالإشريكية القولونية يسبق ذات الرئة ويرجع عادة إلى بؤرة أخرى للعدوى بالإشريكية القولونية في السبيل البولي أو المعدي المعوي.
العداوى داخل البطن Intra-abdominal infections
إن العداوى داخل البطن بالإشريكية القولونية غالبًا ما تنتج عن حشى مثقوب (مثل الزائدة الدودية والرتج) أو يمكن أن تترافق مع خراج داخل البطن والتهاب المرارة والتهاب الأقنية الصفراوية الصاعد ascending cholangitis.
يكون المرضى المصابون بالداء السكري في خطر عالٍ أيضًا لتطور التهاب الوريد البابي وخراجات الكبد. يُشاهَد خراج الكبد بالإشريكية القولونية في الصورة في الأسفل.

تكون الخراجات داخل البطن متعددة المكروبات عادة ويمكن أن يسببها انثقاب السبيل المعدي المعوي الرضحي أو العفوي أو بعد التمزق التفاغري anastomotic disruption مع فيض محتويات الكولون والتهاب صفاق لاحق subsequent peritonitis.
يمكن أن تُلاحَظ في الفترة التالية للجراحة بعد التمزق التفاغري. تكون الخراجات غالبًا متعددة المكروبات، وتُعَد الإشريكية القولونية إحدى العصيات سلبية الغرام الأكثر شيوعًا والتي تُلاحظ مع اللاهوائيات.
ينتج التهاب المرارة والتهاب الأقنية الصفراوية عن انسداد الجهاز الصفراوي من حصاة أو كُدارة صفراوية، مما يؤدي إلى ركود ونمو جرثومي من الحليمات أو الدوران البابي. عندما يُسَد تدفق الصفراء فإن الكائنات الحية القولونية -بما فيها الإشريكية القولونية- تستعمر الصائم والعفج. بصورة ملفتة يكون الانسداد الجزئي أكثر احتمالًا من الانسداد التام لأن يؤدي إلى العدوى وتجرثم الدم وتجرثم الصفراء والحصيات الصفراوية.
العداوى المعوية Enteric infections
يحصل انتقال هذا الشكل من المرض عادةً بالطريق الفموي البرازي، وذلك بتناول طعام أو ماء ملوث بالجرثومة.
حدد حتى الآن على الأقل 5 أنواع من العداوى المعوية تختلف من حيث الآلية الإمراضية: المنتجة للذيفان المعوي (ETEC) والممرضة للأمعاء (EPEC) المسببة للنزف المعوي (EHEC) والغازية للأمعاء (EIEC) والمكدسة في الأمعاء (EAEC).
العامل الممرض في جميعها أساساً هو الإشريكية القولونية، لكن تختلف فقط من حيث اكتسابها للسمات المرضية. فمثلاً يجب الشك بالإصابة بالإشريكية القولونية المسببة للنزيف المعوي عند المرضى المصابين بإسهال دموي حاد، خصوصاً في حال ترافق الإسهال مع مضض بطني وغياب في الحرارة.
لقد سُجِّلت ست آليات مختلفة لعمل ستة أنواع مختلفة من الإشريكية القولونية كسبب للعداوى المعوية.
- الإشريكية القولونية المنتجة للذيفان المعوي Enterotoxigenic E coli (ETEC) هي سبب لإسهال المسافرين.
- الإشريكية القولونية الممرضة للأمعاء Enteropathogenic E coli (EPEC) هي سبب للإسهال عند الأطفال.
- الإشريكية القولونية الغازية للأمعاء Enteroinvasive E coli (EIEC) تسبب زحارًا شبيهًا بالمُسبَّب بالشيغيلة.
- الإشريكية القولونية المنزفة للأمعاء Enterohemorrhagic E coli (EHEC) تسبب التهاب القولون النزفي hemorrhagic colitis أو متلازمة انحلال الدم-اليوريمية hemolytic-uremic syndrome (HUS).
- الإشريكية القولونية المتراكمة في الأمعاء Enteroaggregative E coli (EAggEC) تترافق أصلًا مع إسهال مستديم عند الأطفال في الدول النامية.
- الإشريكية القولونية الملتصقة بالأمعاء enteroadherent E coli (EAEC) هي سبب للإسهال عند الأطفال وإسهال المسافرين في المكسيك وشمال إفريقية.
تستعمر ETEC وEPEC وEAggEC وEAEC الأمعاء الدقيقة، أما EIEC وEHEC فتفضلان استعمار الأمعاء الغليظة قبل أن تسبب الإسهال.
تُعتبَر الإشريكية القولونية المنتجة لذيفان الشيغا Shiga toxin–producing E coli (STEC) من بين الأسباب الأكثر شيوعًا للأمراض المنقولة بالغذاء. ويُعَد هذا الكائن الحي مسؤولًا عن عدة أمراض مَعِدية معوية بما فيها الإسهال المدمى وغير المدمى.
إن المرضى المصابين بهذه الأمراض -خصوصًا الأطفال- قد يتأثرون بمضاعفات عصبية وكلوية تشمل متلازمة انحلال الدم-اليوريمية (HUS). لقد سببت ذراري STEC من النمط المصلي O157-H7 فاشيات متعددة وحالات فرادية من الاسهال المدمى وHUS.
شاهد Kappeli وآخرون 97 من ذراري STEC غير O157 لدى مرضى مصابين بالإسهال ووجدوا أن HUS تطور عند 40% من المرضى. وكان النمط المصلي O26:H11/H مترافقًا في معظم الأحيان مع هذه المتلازمة. على الرغم من أن الذراري المترافقة مع HUS كانت أكثر احتمالًا لتحمل STX2 وEAE بالمقارنة مع تلك المترافقة مع الإسهال المدمى، إلا أن خمسة من أصل ثمانية مرضى مصابين بـ HUSكان لديهم الجين STX2. من بين المرضى الثلاثة الذين كانت لديهم ذراري سلبية EAE وسلبية STX2 فإن STX1 فقط أو STX1 وEHXA سببت HUS.
الإشريكية القولونية المنتجة للذيفان المعوي (ETEC)
تعد هذه الجراثيم مسبباً شائعاً لإسهال المسافرين. يحصل الانتقال عبر الطعام والمياه الملوثين بمخلفات الإنسان، أو بالاتصال من شخص لآخر. تستعمر هذه الجراثيم الأمعاء الدقيقة (تسهل الأهداب الارتباط بالمخاطية المعوية). تسبب هذه الجراثيم في عملية متواسطة بالذيفانات المعوية فرط إفراز مطول لشوارد الكلور والماء من جدر مخاطية الأمعاء، بينما تثبط إعادة امتصاص الصوديوم. تصبح الأمعاء مليئة بالسوائل، ما يؤدي إلى إسهال مائي كبير يستمر لبضعة أيام. تتضمن الذيفانات المعوية ذيفاناً صامداً للحرارة (ST) يعمل على التسبب بارتفاع في مستويات الغوانوزين أحادي الفوسفات الحلقي (cGMP)، بينما الذيفان العطوب بالحرارة (LT) يسبب ارتفاعاً في الأدينوزين أحادي الفوسفات الحلقي (cAMP).
الإشريكية القولونية الممرضة للأمعاء (EPEC)
تعد سبباً هاماً للإسهال عند الرضع، خصوصاً في مناطق سوء الشروط الصحية. يصاب به حديثو الولادة في الفترة المحيطة بالولادة. تلتصق هذه الجراثيم بالخلايا المخاطية في الأمعاء الصغيرة باستخدام أهداب مشكلة للحزم (BfpA). وتدعى الآفات الناتجة في الأمعاء الدقيقة آفات الالتصاق والمحو، بالإضافة لتدمير الزغيبات، وذلك نتيجة حقن بروتينات مستقعلة، في خلايا المضيف بطريقة نظام الإفراز من النمط 3 (T3SS). خلايا الإشريكية القولونية الممرضة للأمعاء ليس جراثيم مرضة، وبذلك لا تسبب إسهالاً دموياً. ويمكن أن تسبب إسهالاً مزمناً في بعض الأحيان.
الإشريكية القولونية المسببة للنزف المعوي (EHEC)
ترتبط بالخلايا في الأمعاء الغليظة عن طريق أهداب مشكلة للحزم (BfpA)، وتنتج (كما في الإشريكية القولونية الممرضة للأمعاء) آفات الالتصاق والمحو. لكن بالإضافة لذلك فهي تنتج أحد ذيفانين خارجيين (الذيفانات الشبيهة بالشيغيلة 1 أو 2)، ما يؤدي إلى شكلٍ شديد من إسهال دموي غزير (التهاب قولون نزفي) في غياب الالتهاب أو الغزو المخاطي. ويعد النمط المصلي O157:H7 هو الأكثر شيوعاً من سلالات الإشريكية القولونية التي تنتج الذيفانات الشبيهة بالشيغيلة. ترتبط هذه السلالة بالإصابة بفشل كلوي حاد مهدد للحياة (متلازمة انحلال الدم اليوريمية HUS) يتسم بحمى وفشل كلوي حاد وفقر دم انحلالي معتل الأوعية الدقيقة ونقص في الصفيحات الدموية عند الأطفال الأصغر من الأعمار 5-10 سنين. العائل الأساسي لهذه الجراثيم هو الماشية. لذلك فإنَّ إمكانية العدوى قد تنقص بشدة من خلال الطبخ الجيد للحم وبسترة الحليب.
الإشريكية القولونية الغازية للأمعاء (EIEC)
تسبب هذه الجراثيم المتلازمة الشبيهة بالزحار وتترافق مع حرارة وبراز مدمى. عوامل الفوعة المرمزة في البلاسميد متطابقة تقريباً مع تلك التي لأنواع الشيغيلة. تسمح عوامل الفوعة هذه بغزو الخلايا الظهارية وبالانتشار داخل الخلوي من خلال استخدام الحركة القائمة على الأكتين. بالإضافة لذلك تنتج السلالات الغازية للأمعاء أنزيم الهيموليزين.
الإشريكية القولونية المكدسة في الأمعاء (EAEC)
تسبب أيضاً هذه الجراثيم إسهال المسافرين، وإسهالاً مستمراً عند الأطفال الصغار. الالتصاق بالأمعاء الدقيقة يتواسطه خمل الالتصاق. تمثل عصيات الالتصاق أحجار طوب متكدسة فوق بعضها، تسبب قصر الزغيبات. تنتج سلالات هذه الجراثيم ذيفاناً صامداً للحرارة يرمز له البلاسميد. وقد سبب انتشار عداوى الإشريكية القولونية في ألمانيا كثيراً من حالات الوفاة.
المرض خارج المعوي
مصدر عدوى المرض خارج المعوي يكون عادةً فلورا المريض المعوية نفسه، تكون فيه الإشريكية القولونية غير ممرضة في الأمعاء؛ لكن تسبب مرضاً عند الأشخاص في حال وصولها للمثانة أو المجرى الدموي (أي عموماً للمناطق العقيمة عادةً).
عداوى السبيل البولي
تعد الإشريكية القولونية السبب الأشيع لعدوى السبيل البولي، جيث تسبب ال E coli أكثر من 90% من عدوى السبيل البولي غير المصحوب بمضاعفات.
بما فيها التهاب المثانة والتهاب الكلية والحويضة. وتكون النساء تحت خطر أكبر للإصابة بالعدوى. وتنتج الإصابة بالتهاب المثانة غير المعقد (الأكثر شيوعاً في عداوى السبيل البولي) عن سلالات ممرضة بولياً من الإشريكية القولونية تتسم بخمل P (عامل التصاق) وتمتلك الهيموليزين والكوليسين V ومقاومة على الفعالية القاتلة للجراثيم للمكونات المصلية. أما عدوى السبيل البولي المعقد (التهاب الكلية والحويضة) فقد يحدث في حال سد التدفق البولي، والذي قد يكون سببه سلالات غير ممرضة بولياً.
تكون نسبة النكس بعد العدوى الأولى بال E coli 44% طوال 12 شهر. تتسبب عداوى السبيل البولي المسببة بال E coli بواسطة سلالات ممرضة بولية من ال E coli.
يسبب ال E coli مجالات واسعة من عداوى السبيل البولي مشتملة على التهابات الاحليل والتهاب المثانة غير المصحوبان بمضاعفات uncomplicated urethritis/ cystitis والتهاب المثانة العرضي symptomatic cystitis والتهاب الحويضة والكلية pyelonephritis والتهاب البروستات الحاد acute prostatitis وخراجات البروستات prostatic abscess والإنتانات البولية urosepsis.
يحدث التهاب المثانة أولاً عند النساء النشيطين جنسياً واستعمرن بواسطة سلالات ممرضة بولية من ال E coli. ومن ثم تستعمر المنطقة المحيطة بالاحليل من التلوث في الكولون، ويصل الكائن الحي إلى المثانة من خلال الاتصال الجنسي.
تملك السلالات الممرضة البولية من الـ E coli عامل مقاومة يدعى الخمل ب P fimbriae أو الأشعار pili والتي ترتبط إلى مستضد الزمرة الدموية P. يتوسط هذا الخمل ب التصاق ال E coli إلى الخلايا البطانية البولية. وبالتالي يكون المرضى الذين لديهم حمولة معوية من ال E coli التي تحتوي على الخمل ب أعلى خطورة لتطوير عداوى السبيل البولي بالمقارنة مع المرضى العامين.
تلاحظ عداوى السبيل البولي المصحوبة بمضاعفات والتهاب الحويضة والكلية في المرضى كبار السن المصابين بشذوذات بنيوية أو انسداد مثل تضخم البروستات أو المثانات عصبية المنشأ أو في المرضى الذين يستخدمون قثاطر بولية. يظهر التهاب الحويضة والكلية اليمنى بال E coli في الصورة أسفل.

عادة ما يترافق تجرثم الدم بال E coli مع عداوى السبيل البولي، وخاصة في حالة انسداد السبيل البولي لأي سبب. يمكن أن تقود الإستجابة الجهازية للذيفان الداخلي (سيتوكينات) أو عديدات السكاريد الشحمية إلى التخثر المنتشر داخل الخلايا disseminated intravascular coagulation والموت.
عتبر ال E coli المسبب الرئيسي لتجرثم الدم المكتسب بالمشفى من مصدر الجهاز المعوي المعدي أو الجهاز البولي التناسلي.
عداوى أخرى
تشتمل عداوى ال E coli الأخرى المتنوعة على التهاب المفاصل الخمجي septic arthritis والتهاب باطن المقلة endophthalmitis والتهاب الغدة الدرقية القيحي suppurative thyroiditis والتهاب الجيوب والتهاب العظم والنقي osteomyelitis والتهاب شغاف القلب وعداوى الجلد والأنسجة الرخوة (وخاصة في المرضى المصابين بالسكري).
العداوى المكتسبة في المستشفى
تتضمن هذه العداوى تجرثم الدم والصدمة بالذيفان الداخلي والتهاب الرئة.
التشخيص السريرية والمخبري
الدراسات المخبرية
يجب أن يخضع المرضى المشكوك بإصابتهم بعدوى E coli إلى تعداد دم كامل CBC روتيني مع التميز للتقييم من أجل كثرة الكريات البيضاء leukocytosis أو عكس ذلك.
تحدد نتائج تلوين غرام إذا كان الكائن الحي سلبي الغرام، ولكن لايمكن تمييز الموجودات فيما بين العصيات سلبية الغرام الهوائية الأخرى والتي تسبب أمراض معدية مشابهة.
الـ E coli هي عصية سلبية الغرام تنمو بشكل جيد على الأوساط المستخدمة بشكل عام. هي مخمرة للاكتوز وحالة للدم من النمط بيتا على أغار الدم. معظم سلالات ال E coli غير مصطبغة.
تظهر الصورة في الأسفل ال E coli على تلوين غرام. نستطيع أن نرى في الصورة في الأسفل ال E coliالنامي على وسط ماكونكي(يسار)

تعتمد التشخيصات المحددة على عزل الكائن الحي في المخبر الميكروبيولوجي من العينات السريرية. يمكن أن تكون العينات دم أو بول أو قشع أو السوائل الأخرى مثل السائل الدماغي النخاعي والصفراوي والخراجات والصفاقي.
يجب أن يحلل الحصول على الكائن الحي في الأماكن الملوثة مثل القشع والجروح في اطار حالة المريض السريرية لتحديد إذا كان ذلك يمثل الاستعمار أو العدوى.
يجب أن يعتبر الحصول عليه من الأماكن العقيمة مثل السائل الدماغي الشوكي تشخيص للعدوى.
يثبت البزل القطني وإيجابية زرع السائل الدماغي الشوكي لل E coli التشخيص بالتهاب السحايا الحاد المسبب بال E coli، ومع ذلك فإن البزل القطني غير مسموح به لدى جميع الرضع المترافقين مع خمج دم.
إن استطبابات البزل القطني تشتمل على نتائج زرع دم إيجابية وإشارات عصبية غير طبيعية وكشف المستضدات الجرثومية في البول.
يجب أن يخضع المرضى المصابين بذات الرئة إلى زروع دموية وزرع وتلوين غرام للقشع. حيث تساعد نتائج تلوين غرام للقشع بتمييز العينة الجيدة (العديد من الكريات البيض العدلات والقليل من الخلايا البطانية) عن العينة السيئة (القليل من الكريات البيض العدلات والعديد من الخلايا البطانية). بالإضافة إلى أنه يجب الحصول على مزرعة القشع قبل البدء بالمعالجة بالصادات الحيوية.
يشارإلى الكائن الحي المسبب في العداوى المعوية اعتماداً على العرض السريري وتمييز براز المريض. تنتج عداوى ال E coli المسببة بالأنواع التالية ETEC و EPEC و EAggEC و EAEC برازات مائية من دون خلايا التهابية. تنتج العدوى بال EIEC برازات من النوع الزحاري وتنتج العدوى بال EHEC برازات من النوع النزفي.
يمكن أن يجرى اختبار غميسة البول urine dipstick test في عداوى السبيل البولي للتحديد السريع لاصابة المريض ببيلة قيحية أو بيلة جرثومية بالاعتماد على كشف استراز ونتريتات الكرية البيضاء على التوالي. يعتمد التشخيص الحاسم على نتائج زرع البول.
أجمع العينة من منتصف الجريان النظيف لإفراغ المثانة أو من القثاطر في المرضى مع قثطرة فولي indwelling Foley catheter. يجب أن يميز الاستعمار عن العدوى بالإعتماد على نتائج تحليل البول.
الدراسات التصويرية
يوصى في ذات الرئة بإجراء التصوير الشعاعي للصدر أو المسح المقطعي المحوسب CT]] scanning]]
يوصى في التهاب المرارة/التهاب الأقنية الصفراوية إجراء تخطيط الصدى ultrasonography أو المسح المقطعي المحوسب في الربع الأعلى الأيمن.
يوصى في الخراجات داخل البطن، البطنية والحوضية بإجراء المسح المقطعي المحوسب، يمكن أن تفقد الخراجات في الأمواج فوق الصوتية.
يمكن أن يجرى المسح المقطعي المحوسب أو تخطيط الصدى في عداوى السبيل البولي لمشاهدة أي مصدر آخر من الخراجات أو الحصى أو الانسداد.
اختبارات أخرى
يمكن أن تميز سلالات ال E coli المسببة للإسهال بالاعتماد على النتائج من الاختبارات غير واسعة الاستخدام مثل مسابير الدنا DNA probes وال (PCR) polymerase chain reaction.
يمكن أن يميز ال EPEC بالاعتماد على الموجودات من التنميط المصلي ومقايسة الالتصاق ومسابير الدنا. هذه الاختبارات صعب اجرتؤها وغير متوفرة بشكل واسع، أيضاً من الصعب تفسير النتائج.
يمكن أن يميز ال EIEC بالاعتماد على النتائج من الاختبارات الإمراضية الحيوانية مثل اختبار سيريني Sereny test.
يمكن أن يميز ال EHEC عبر مشاهدة النمط المصلي الرئيسي المشتمل على O157:H7.
تزرع سلالات ال EHEC في أغار ماكومكي سوربيتول. تنمط السلالات التي تكون سلبية السوربيتول مع O157:H7 antisera.
تميز EAggEC و EAEC بالاعتماد على نموذج التصاقها على خلايا المزرعة النسيجية.التنميط غير مفيد.
الإجراءات
يمكن أن تشير الإجراءات التالية إلى:
- التهاب السحايا: البزل القطني مع زرع وتلوين غرام للسائل الدماغي الشوكي.
- ذات الرئة: التنظير القصبي مع زرع البول والدم.
- التهاب المرارة / التهاب الأقنية الصفراوية إزالة الضغط من الجهاز الصفراوي عبر الإفراغ بالتنظير الداخلي أو بضع المصرة من أجل نزع الحصاة أو تصوير الأقنية الصفراوية بالتنظير الداخلي.
- الخراجات داخل البطن عبر الارتشاح والإفراغ.
- عدوى السبيل البولي في حالة الانسداد الحالبي في حالة نزع الحصاة أو الدعامة.
- تضخم البروستات- استئصال البروستات بطريق الاحليل أو استئصال جزئي بالجراحة للبروستات عن طريق الاحليل (TURP).
- خراجات البروستات – الإفراغ.
الكشف في المختبر
في حالة الداء المعوي
لكون الإشريكية القولونية جزءاً طبيعياً من الفلورا المعوية فإنَّ كشف السلالات الممرضة منها في مزارع البراز صعب للغاية.
لا تخمر الإشريكية القولونية الغازية للأمعاء اللاكتوز، ويمكن كشفها على وسط مثل وسط ماكونكي آغار. أما الإشريكية القولونية المسببة للنزف المعوي فبخلاف معظم سلالات الإشريكية القولونية فهي تخمر السوربيتول ببطء في حال خمرته، ويمكن كشفها على سط ماكونكي سوربيتول آغار. ويمكن توظيف التقنيات الجزيئية الحالية (مثل تفاعل البوليمراز المتسلسل) لكشف سلالات الإشريكية القولونية المنتجة للذيفان الشبيه بالشيغيلة.
المرض خارج المعوي
يعد عزل الإشريكية القولونية من مواقع الجسم العقيمة (مثل المثانة والسائل الشوكي) ذا أهمية تشخيصية.
يمكن زرع العينات المأخوذة على وسط ماكونكي آغار.
الرعاية الطبية
تعتمد الرعاية الطبية لعدوى ال E coli على موقع وخطورة العدوى. بالإضافة إلى الصادات الحيوية يجب تأمين رعاية دائمة مثل الإماهة والأكسجة الملائمة ودعم ضغط الدم إذا أشير إلى ذلك.
الرعاية الجراحية
- يمكن أن يوصى بالإفراغ الجراحي وإزالة الضغط في المرضى المصابين بالتهاب المرارة/التهاب الأقنية الصفراوية.
- يمكن أن يوصى بالإنضار الجراحي من أجل هؤلاء المرضى مع خراجات داخل البطن.
- يمكن أن يوصى بالإستئصال الجزئي بالجراحة للبروستات عن طريق الاحليل (TURP) في المرضى مع انسداد السبيل البولي مثل تضخم البروستات. في بعض الحالات تتوضع الدعامات الحالبية من أجل إعاقة الحصى الكلوية، ومع ذلك تزال هذه الدعامات قدر الإمكان.
يبدأ الإفراغ الجراحي الملائم من أجل الخراجات الكبدية باستخدام نزع الغطاء بطريق الإحليل transurethral unroofing أو الشق العجاني perineal incision.
الحمية Diet
يجب أن يعطى الطعام لمنع سوء التغذية خلال حادثة الإسهال المسبب بالـ E coli
الفعالية Activity
يمكن أن تستمر الفعالية حسب مقاومة المريض.
المعالجة
- يعد الحفاظ على توازن الكهرليات والسوائل في الجسم ذا أهمية شديدة في العاج.
- يمكن أن تنقص الصادات الحيوية من مدة الأعراض، لكن تنتشر كثير من السلالات المقاومة. ويتطلب الداء خارج المعوي علاجاً بالصادات الحيوية، لذا فاختبار الحساسية على الصادات الحيوية ضروري لتحديد الخيار المناسب من الأدوية.
- يتطلب التهاب السحايا المسبب بال E coli صادات حيوية مثل سيفالوسبورينات الجيل الثالث(سيفترياكسون).
- يتطلب ذات الرئة بال E coli دعم تنفسي وأكسجة ملائمة وصادات حيوية مثل سيفالوسبورينات الجيل الثالث والفلوروكينولونات.
- يتطلب التهاب المرارة/التهاب الأقنية الصفراوية صادات حيوية مثل سيفالوسبورينات الجيل الثالث التي تغطي المتعضيات ال E coli والكلبسيلا. يجب أن تشتمل التغطية التجريبية أيضاً على تغطية مضادة للقولونيات البرازية E faecalis.
- يجب أن تشتمل الصادات الحيوية من أجل ال E coli المسببة للخراجات داخل البطن تغطية لا هوائية (مثل الأمبيسيلين والسولباكتام sulbactam أو سيفوكستين cefoxitin. يمكن أن يستخدم في العدوى الخطيرة البيبراسيلين piperacillin والتازوباكتام tazobactam أو إيميبينيم imipenem والسيلاستاتين cilastatin أو الميروبينيم meropenem. يمكن أن تستخدم المعالجة المشاركة بالصادات الحيوية والتي تغطي ال E coli زائد مضاد لا هوائي (مثل الليفوفلوكساسين + الكليندامايسين أو الميترونيدازول).
- تتطلب العداوى المعوية بال E coli تعويض سوائل مع أملاح حاوية على شوارد ملائمة. تكون الأدوية المضادة للميكروبات المعروفة مفيدة في حالة اسهالات المسافرين وتشتمل على الدوكسيسيكلين والتريميتوبريم/سلفاميتوكسازول (TMP/SMZ) والفلوروكينولونات والريفاكسامين rifaximin. تقوم هذه الأدوية بتقصير مدة الاسهال بحوالي 24-36 ساعة. من غير المفيد استخدام الصادات الحيوية في عدوى ال (EHEC) وربما تؤهب لتطور مُتَلاَزِمَةُ انْحِلاَلِ الدَّمِ-اليوريمية HUS.
يمنع استعمال العوامل المضادة للحركة عند الأطفال والأشخاص المصابون بعدوى EIEC.
- يمكن أن يعالج التهاب المثانة بال E coli بجرعة وحيدة من الصاد الحيوي أو 3 كورسات جرعية من الفلوروكينولون أو TMP/SMZأو النتروفورانتوئين.
- يعالج التهاب المثانة الناكس (حدوث أكثر من مرتين بالسنة) بشكل مستمر أو بشكل وقائي بعد الجماع مع الفلوروكينولون أو TMP/SMZأو النتروفورانتوئين.
- يعالج المرضى الذين لديهم حالات معقدة (مثل السكري، أكبر من 65 سنة أو تاريخ حديث بالاصابة بعدوى السبيل البولي) مع مساق من 7 إلى 14 يوم من الصاد الحيوي (مثل ليفوفلوكساسين أو [[سيفالوسبورينات] الجيل الثالث أو ازترونام (aztreonam.
- يعالج التهاب الحويضة والكلية الحاد غير المصحوب بمضاعفات عند النساء الشباب بالفلوروكينولون أو TMP/SMZ لمدة 14 يوم.
يجب أن يقبل المرضى الذين لديهم إقياء أو غثيان أو أمراض أساسية (مثل السكري) في المستشفى. إذا استمرت الحرارة أو ألم الخاصرة لأكثر من 72 ساعة يجب اجراء المسح المقطعي المحوسب أو تخطيط الصدى.
- تعالج الخراجات المحيطة بالكلية أو التهاب البروستات المسببة بال E coli بالصادات الحيوية لمدة لاتقل عن 6 أسابيع.
- يتطلب خمج الدم المسبب بال E coli على الأقل أسبوعين علاج بالصادات الحيوية مع تحديد مصدر تجرثم الدم بالاعتماد على نتائج الدراسة التصويرية.
- وجد McGannon et أن الصادات الحيوية التي تستهدف اصطناع الدنا مثل السيبروفلوكساسين (CIP) وTMP/SMZ أظهرت ازدياد في انتاج ذيفان الشيغا Shiga، بينما لا تفعل ذلك الصادات الحيوية التي تستهدف الجدار الخلوي أو الانتساخ أو الترجمة. بشكل لافت للنظر، كشفت مستويات عالية من ذيفان الشيغا أيضا عند نمو O157:H7 المكبوح تماماً بواسطة السيبروفلوكساسين. بشكل مغاير قلل الأزيترومايسين بجدية مستويات ذيفان الشيغا حتى عند بقاء عيوشية O157:H7 عالية.
- منذ أواخر 1990، برزت العديد من الأدوية المقاومة من قبل الإمعائيات (معظمها ال E coli) والتي تنتج بيتا لاكتاماز واسعة الطيف ESBLs مثل أنزيمات ال CTX-M ضمن صلب المجتمع كمسبب رئيسي لعداوى السبيل البولي. هذه البكتريا مقاوم لمجموعات الصادات الحيوية شائعة الاستخدام لعلاج هذه الأنواع من العدوى (البنسيلينات والسيفالوسبورينات)، والصادات الحيوية التي عادة ما يتحفظ على استخدامها للعداوى الشديدة (مثل الفلوروكينولونات والجينتامايسين).
- يغير إلى حد بعيد انتشار الجراثيم إيجابية ال CTX-M كيفية علاج العداوى المكتسبة بالمجتمع ويمكن أن تعطى الصادات الحيوية الفموية المحدودة والمعالجة. يملك هذا الكشف مضامين هامة من أجل معالجة الأشخاص الذين لم يستجيبو سريرياً للخط الأول من الصادات الحيوية.
- في أحد الدراسات، كان معدل الوفيات التالي لعدوى تجرثم الدم المسبب بواسطة ال E coli المنتجة لل ESBL أعلى بشكل واضح من ال E coli غير المنتجة لل ESBL. لدى هذه الموجودات مضامين جدية من أجل وصف الصادات الحيوية، كسيفالوسبورينات تكون علاج غير فعالة من أجل العديد من عداوى ال E coli.
- لوحظت العدوى الناتجة عن ال E coli المنتجة لل ESBL بشكل كبير كظاهرة مرافقة للرعاية الصحية. ومع ذلك بدأ بزوغ التقارير للعداوى المكتسبة بالمجتمع المسبب بواسطة ال E coli المنتجة لل ESBL وميزت هذه الحادثة من العدوى المكتسبة بالمجتمع نتيجة ال E coli المنتجة لل ESBL بين مرضى من دون عوامل خطورة مرافقة للرعاية الصحية القابلة للتمييز في الولايات المتحدة الأمريكية.
تسبب معظم السلالات المنتجة لل ESBL (54.2%) أحداث مكتسبة في المجتمع تعود إلى ST131 أو إلى الأنماط المتعاقبة المرتبطة. مابين هذه السلالات جميعها باستثناء واحدة تنتج CTX-M–type ESBL، بشكل خاص CTX-M-15.
المصدر
https://emedicine.medscape.com/article/217485-overview
Richard A. Harvey, Lippincott’s Illustrated Reviews microbiology, third edition, Wolters Kluwer, P.P. 111-15.